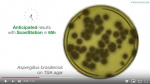

Scan 3000 АI — это автоматический счетчик цветных колоний, который использует искусственный интеллект (ИИ), прибор обеспечивает высокую точность и превосходную производительность, внедряя инновационные технологии. Он адаптирован для подсчета на чашках Петри до 90 мм и всех типах питательных сред.
Особенности автоматических счетчиков колоний Interscience:
- благодаря ИИ эффективность подсчета на 25% выше, в отличии от стандартного счетчика колоний;
- точность подсчета до 98%;
- автоматизированное считывание антибиотикограмм (до 7 антибиотиков за 1-3 секунды);
- распознавание артефактов;
- пользователь визуально контролирует изображение;
- подсчет колоний на чашках Петри со спиральным посевом;
- улучшенная минимальная конфигурация ПК с использованием графической карты Nvidia;
- обновленный интерфейс;
- новая опция настройки экспорта в формате PDF для эффективного регулирования детализации отчетов;
- 2 технологии нумерации колоний: классическая и технология ИИ.
Счетчик колоний автоматический Scan 3000 АI — прибор для автоматического подсчета и определения зон ингибирования антибиотиков и документирования.
Характеристики автоматического счетчика колоний Scan 3000 АI, Interscience:
- минимальный размер колоний, мм — 0,03;
- автоматический подсчет колоний за 1 секунду;
- счет на чашках Петри, d 55-90 мм;
- улучшенное изображения камеры разрешение 5 МП;
- освещение — белый светодиодный купол;
- считывание зон ингибирования: антибиограмма на кровяном агаре, антибиограмма на агаре Мюллера-Хинтона;
- счет колоний на фильтрах Petrifilm, CompactDry, MC-Media Pads Easy Plate, фильтрационных мембранах;
- счет колоний на хромогенном агаре;
- габариты Ш×Г×В, мм — 320×320×440;
- вес, кг — 13.